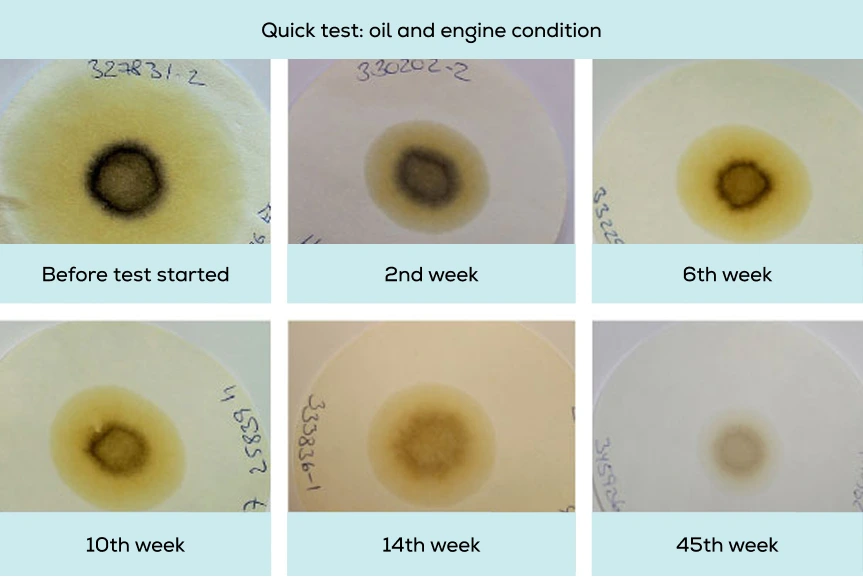

The benefits of offline oil filtration systems from C.C.JENSEN
Offline filtration or kidney loop filtration delivers similar or better quality oil compared to a conventional separator. C.C.JENSEN offers new filtration system technology that revolutionizes the way lube oil is maintained on two- and four-stroke engines across all fuel types. As a global authorized partner of C.C.JENSEN, we at Everllence (former MAN Energy Solutions) are offering the CJC engine lube oil filtration systems, tested by Everllence PrimeServ, to prolong the service life of your engine, reduce maintenance costs, and improve environmental performance.
Benefits of installing a C.C.JENSEN lube oil filter
Main benefits compared to a conventional separator:
- Up to 60% less oil consumption on four-stroke engines
- Up to 20% less oil consumption on two-stroke engines
- 99% lube oil sludge reduction
- 97% fuel savings compared to a conventional separator, contributing to the Carbon Intensity Indicator (CII)
- Two to 10 times longer oil and component lifetime
- No preheating of oil is required
Additional benefits:
- Return on investment (ROI) under one year
- Cost efficiency and easy maintenance
- Offline system does not require the main system to shut down for maintenance or filter changes
- Continuous cleaning 24/7, 365 days a year
- Controlled, scheduled oil replacement
Explore the benefits Stolt-Nielsen achieved with engine lube oil filters
After installing 10 engine lube oil filters, Stolt-Nielsen, a global leader in chemical tanker transportation, conducted extensive efficiency research to evaluate financial and operational benefits. This research is based on measurable factors, such as lube oil quality, filter consumption, and purifier running hours, along with feedback from the crew working directly with the filter units.

Quick test: Efficient oil care
The quick test shows that the lubricating oil was heavily contaminated with dust, metal abrasion, and other particles before and at the beginning of the test period. Oil aging signs and high water content were detected. Thermal load on so-called hot spots (e.g. bearings) and particles from component wear (copper, iron, aluminum) accelerate the degradation of the base oil as well as of the additives and thus the oil aging process.
The efficient oil care from the C.C.JENSEN filtration system permanently removed particles, water, oil aging products, and acid compounds. The oil cleanliness throughout the test period significantly improved.
Our services
We offer several services to make the most of your C.C.JENSEN oil filtration system:
- Support and advice on choosing the right filtration system
- Retrofit installations, new installations, spare parts, and replacement filter insertions with short delivery times
- ROI calculation to evaluate your savings

Calculate savings and ROI for your vessel
We offer a complementary report that analyzes your vessels and demonstrates what results you can expect after installing a C.C.JENSEN oil filtration system. The report will show projected savings with respect to fuel, oil sludge production, and CO₂ emissions. Together with our ROI calculator, the report will summarize the full business case. Please do not hesitate to contact our experts for more information, or directly fill out the form below.

Catch up on the latest Everllence ExpertTalk session
We explored the future of lube oil maintenance for two- and four-stroke engines, regardless of fuel type. Hosted by Andre Douwenga (Product Manager, Everllence PrimeServ) and Steffen Dalsgaard Nyman (Corporate Trainer, C.C.JENSEN), the informative session gives insights into CII improvement, savings, and ease of operation with C.C.JENSEN lube oil filtration systems.

Cost comparison between the centrifuge and CJC lube oil filter

Main engine
Engine:
Stroke: two-stroke
Power rating: 9,000 kW
Quantity: 1
Centrifuge:
Flow: 4,468 l/h
Quantity: 1
By using a CJC lube oil filter instead of a conventional centrifuge:
- Operational expenses reduced by 52%
- Carbon footprint reduced by 94%
Aux engine
Engine:
Stroke: four-stroke
Power rating: 1,150 kW
Quantity: 4
Centrifuge:
Flow: 959 l/h
Quantity: 2
By using four CJC lube oil filters instead of a conventional centrifuge :
- Operational expenses reduced by 53%
- Carbon footprint reduced by 98%

Important numbers
Facts about C.C.Jensen luble oil filters
energy savings compared to a conventional separator
lube oil sludge reduction compared to a conventional separator
return on investment
Why Everllence PrimeServ?
- Global authorized partner of C.C.JENSEN
- Single global point of contact for the service of engines, turbochargers, and other auxiliary equipment
- Original equipment manufacturer (OEM) supply chain
- Everllence PrimeServ warranty (terms and conditions apply)
- Minimal flight and hotel costs for field engineers thanks to total geographic coverage of our service centers

Contact our experts
Find your nearest service center
In addition to C.C.JENSEN filtration technology, Everllence PrimeServ provides service for your critical equipment and components in the engine room, regardless of OEM. Are you in need of urgent service on your fleet or plant? Contact your nearest service center.Resource hub
Find even more information about C.C.JENSEN
Downloads




Omnicare services


